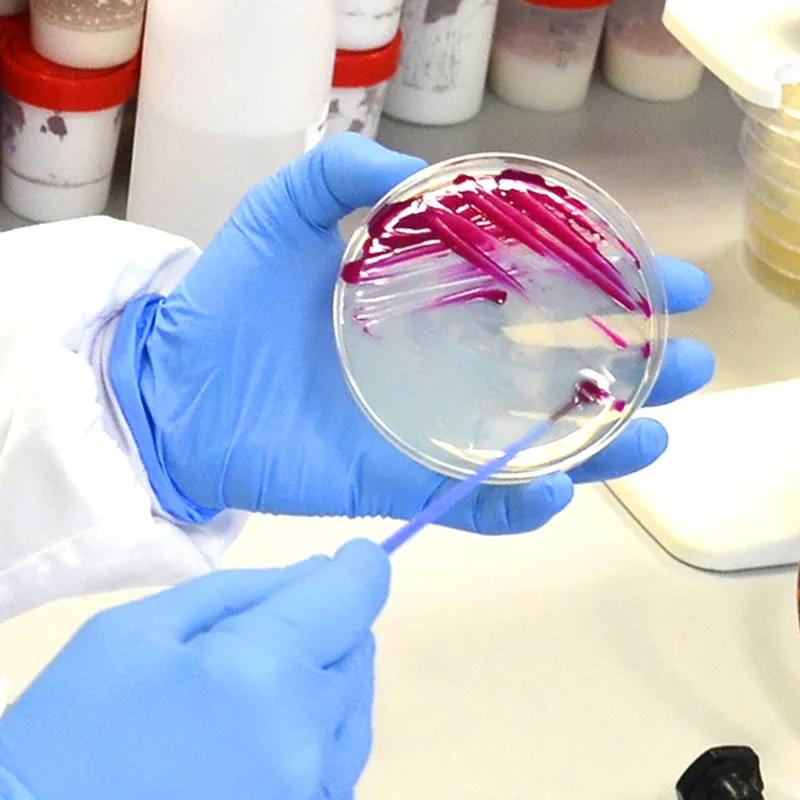

Research and Development
Our drive to solve industry’s toughest challenges is fuelled by a lifetime of scientific research and development. Where there are problems, our curiosity and pursuit of new ideas drives the evolution of innovative new solutions.
&w=3840&q=75)
&w=3840&q=75)
&w=3840&q=75)
&w=3840&q=75)
Solve with ingenuity. Deliver with integrity.
We are committed to exploring every possibility, pushing the boundaries of what's possible, and delivering solutions that not only meet but exceed expectations. This dedication ensures that our products are at the forefront of technology, providing unparalleled performance and reliability in every application. Better for customers, better for consumers, and better for the planet.
Our process
Each process is unique, just like its end product. It begins with a comprehensive understanding of the problem and requirements, then our scientists flex their innovative chemistry expertise. We support through the rollout phase and continue to monitor for efficacy and ongoing optimisations.
Case Studies
&w=3840&q=75)
The role of biocides in long-lasting odour-free water-based emulsion paints
The role of biocides in long-lasting odour-free water-based emulsion paints
&w=3840&q=75)
The Science Behind Cleaner Facades: AMME® Reduces Biocide Runoff
A full year of rain, wind, and weather. That’s what it took for the Fraunhofer Institute for Building Physics (IBP) to run one of the most telling studies on façade coatings in recent memory. Their goal was simple: to understand how much biocide leaches out of coatings once exposed to the real world; not a lab, not a simulation. The breakthrough? Coatings made with THOR’s AMME® microencapsulation technology released up to 85% less biocide than conventional systems. And that’s not speculation. That’s field data.
&w=3840&q=75)
Customised Coater-Ready Solutions Empowering Safer, Smarter Flame Retardancy
In today’s world, your success depends on solutions that are as adaptable and forward-thinking as you are. When industry regulations change, it's important to know that your solutions partners are ready to innovate, fast. That’s why we’re proud to offer one of the most customer-driven innovations in flame retardant technology: the Aflammit® TLC series.
About us
Where we help
Where we help
Our portfolio and bespoke capabilities enable the extraordinary in many sectors.
Discover where we can helpProducts
Products
Our sector-spanning solutions are ready to work for you. Search them here
Discover our products&w=3840&q=75)
&w=3840&q=75)
&w=3840&q=75)
&w=3840&q=75)
&w=3840&q=75)
&w=3840&q=75)
&w=3840&q=75)
&w=3840&q=75)
&w=3840&q=75)
&w=3840&q=75)
&w=3840&q=75)